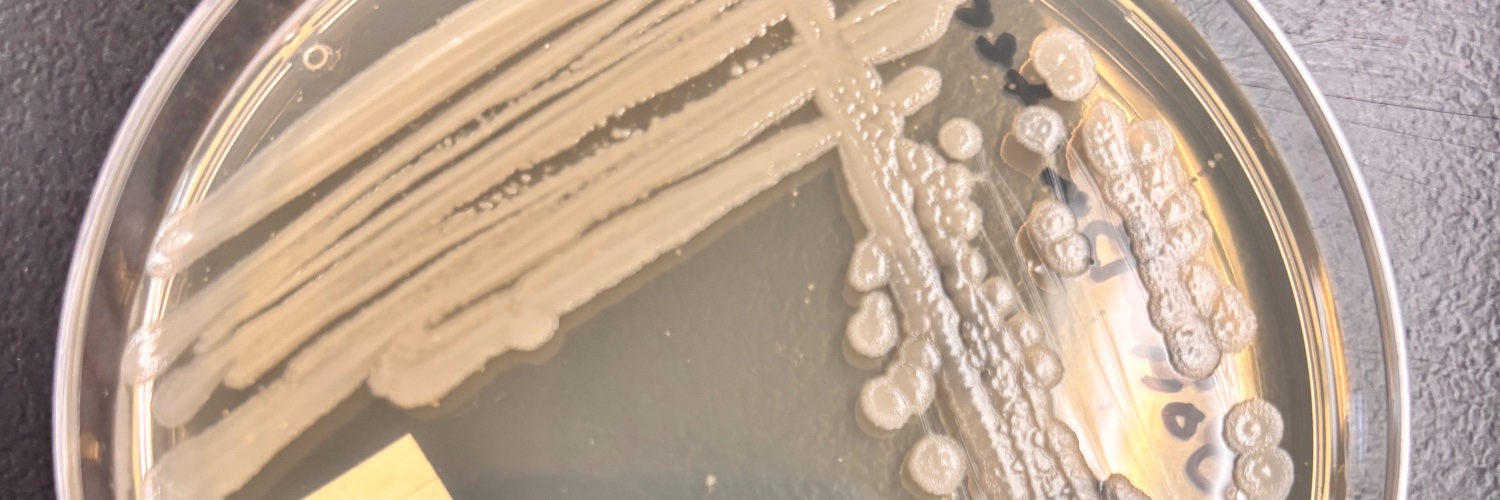
Student banner

@ezralevant Universities are going bankrupt and things are very bad the student cuts have been detrimental to our economy. Please use your brain and look at the data.
English
Student
209 posts

We need massive and immediate reduction in incoming international students. We do not have housing, jobs and health care. Yet the Carney Liberals continue with another half-million students this year. Immigration levels must be cut to bring down population while we focus on jobs, homes and health care for Canadians.










NDP MP Jenny Kwan doesn’t rule out crossing the floor to join the Liberals.





